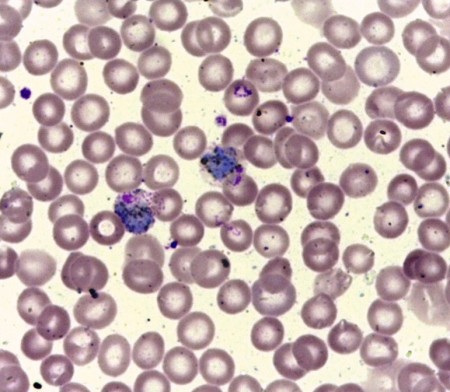

Fase de inscrições acaba em 25/02 (imagem: Calicut Medical College/Wikimedia Commons)
Candidato deve ter conhecimentos em citometria, produção e purificação de proteínas recombinantes, ensaios imunoenzimáticos, PCR e clonagem
Candidato deve ter conhecimentos em citometria, produção e purificação de proteínas recombinantes, ensaios imunoenzimáticos, PCR e clonagem

Fase de inscrições acaba em 25/02 (imagem: Calicut Medical College/Wikimedia Commons)
Agência FAPESP – O Projeto Temático “Explorando o duplo papel de CD98hc na eritropoiese humana e na malária vivax” oferece uma vaga de treinamento técnico nível cinco (TT-5) em imunologia e parasitologia com bolsa da FAPESP. O prazo de inscrição se encerra na próxima quarta-feira (25/02).
As atividades do projeto são exercidas no Instituto de Ciências Biomédicas da Universidade de São Paulo (ICB-USP).
O candidato deve possuir doutorado em imunologia, parasitologia, microbiologia, biologia molecular ou áreas afins, com conhecimento em citometria, produção e purificação de proteínas recombinantes, ensaios imunoenzimáticos, PCR e clonagem. Também são exigidas capacidade de trabalhar em ambiente multidisciplinar e habilidade de comunicação e escrita em inglês.
Mais informações sobre a vaga e as inscrições em: www.fapesp.br/oportunidades/9025/.
A Bolsa TT-5 é voltada a profissional graduado, com pelo menos cinco anos de experiência após a graduação ou título de doutorado (preferível doutor em computação), com dedicação de 40 horas semanais às atividades de apoio ao projeto de pesquisa. O valor da bolsa é de R$ 9.760,00 mensais.
Mais informações sobre as bolsas de Treinamento Técnico da FAPESP: www.fapesp.br/bolsas/tt.
Outras vagas de bolsas, em diversas áreas do conhecimento, estão no site FAPESP-Oportunidades, em www.fapesp.br/oportunidades.
Republicar
A Agência FAPESP licencia notícias via Creative Commons (CC-BY-NC-ND) para que possam ser republicadas gratuitamente e de forma simples por outros veículos digitais ou impressos. A Agência FAPESP deve ser creditada como a fonte do conteúdo que está sendo republicado e o nome do repórter (quando houver) deve ser atribuído. O uso do botão HMTL abaixo permite o atendimento a essas normas, detalhadas na Política de Republicação Digital FAPESP.





